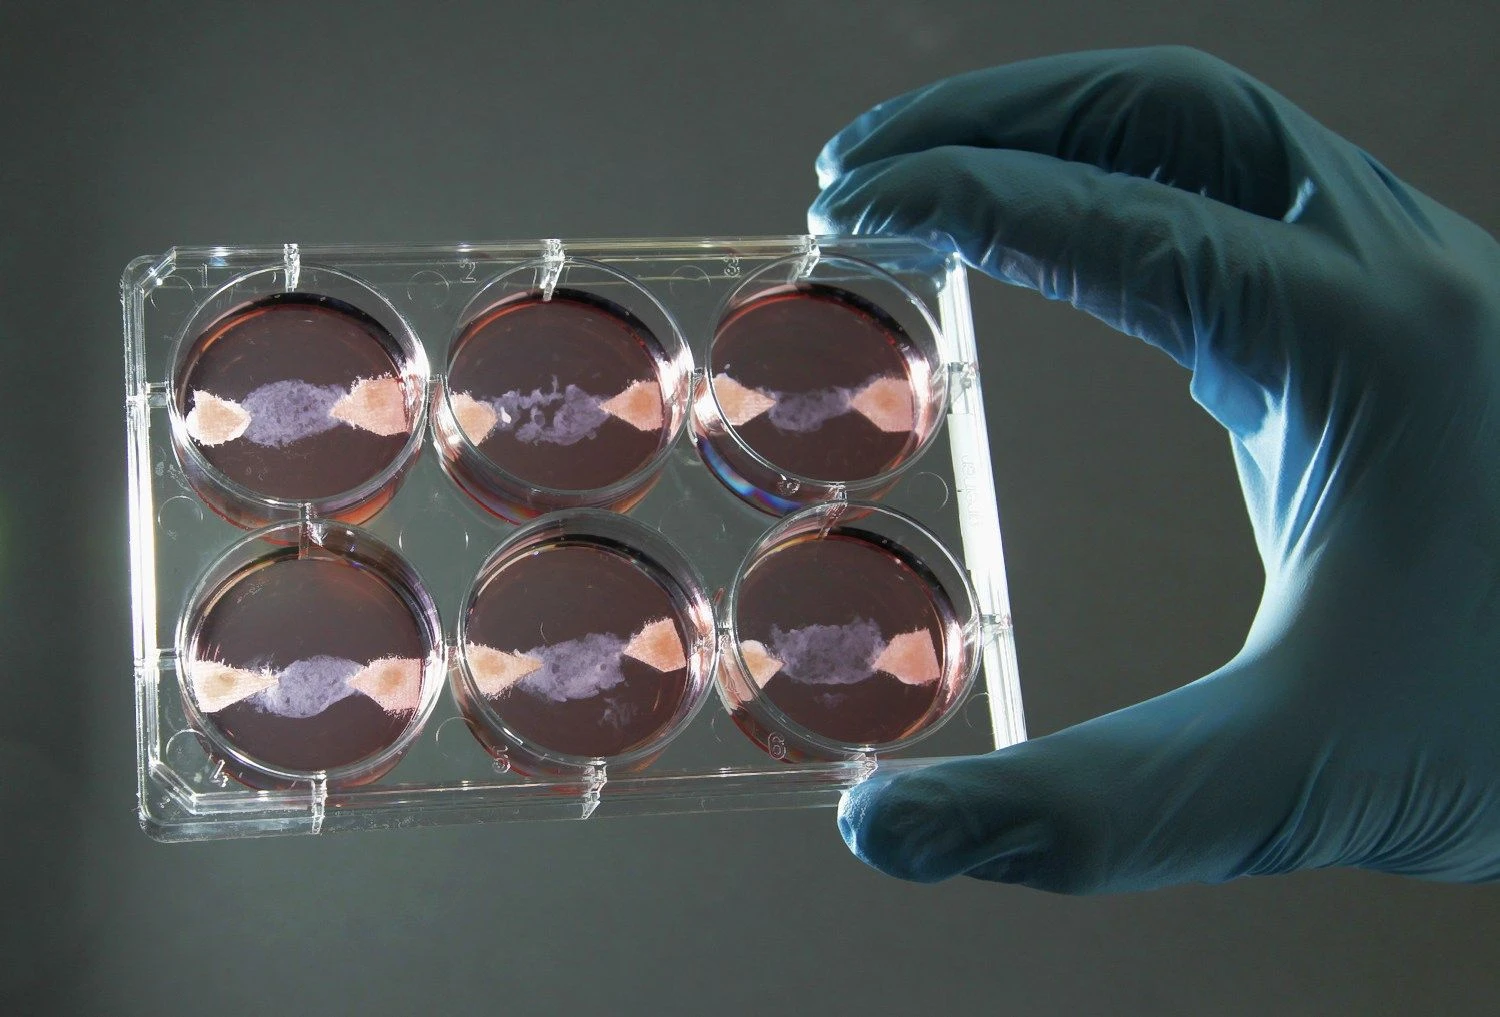
Francois Lenoir („Reuters“ / „Scanpix“) nuotr.

Laboratorijoje užaugintą kepsnį pietums patiekti žada po trejų metų
Viena tokių įmonių, pastaruoju metu itin garsiai skelbiančių, kad iššūkį sugebės įveikti pirmoji, yra San Franciske trijų mokslininkų įsteigta „Memphis Meats“.
Įmonės įkūrėjai įsitikinę, kad jau po trejų ar ketverių metų galėtų pradėti prekiauti laboratorijoje užauginta mėsa, rašo „The Wall Street Journal“.
Vos tik prieš kelias savaites įmonė paskelbė apie savo planus, į lenktynes įsitraukė dar dvi iki šiol tyliai savo tyrimus vykdžiusios JAV kompanijos – „Mosa Meat“ ir „Modern Meadow“. Dabar vien JAV veikia mažiausiai dešimt panašius tyrimus vykdančių bendrovių.
Kilnus tikslas
Apie panašius planus mokslininkai vis prabyla jau kone dešimtmetį, tačiau jų ketinimai įprastai sutinkami skeptiškai ir net priešiškai.
Vieni didžiausių JAV mėsos perdirbėjų „Tyson Foods“ ir „Hormel Foods“ apskritai atsisako komentuoti mokslininkų planus, sakydamos, kad jų technologijos yra pernelyg naujos.
Vis dėlto dabar, kai pasaulyje tiek daug kalbama apie klimato kaitą, augančią žmonių populiaciją ir maisto trūkumą, mintys apie laboratorijose auginamą mėsą priimamos vis natūraliau.
„Mėsos pramonė žino, kad jos produkcijos gamyba nėra tvari. Mes manome, kad po dvidešimties metų didžioji dalis parduotuvėse parduodamos mėsos bus užauginama moksliniais metodais“, - sako Uma Valeti, „Memphis Meats“ vadovas.
Jungtinių Tautų organizacijos duomenimis, gyvulininkystės ūkiai pasaulyje sunaudoja maždaug trečdalį visų užauginamų grūdų, svariai prisideda prie klimato kaitos.
Laboratorijose auginant mėsą išvengiama didelio kiekio atliekų, nesunaudojama tiek daug vandens, visiškai nereikia antibiotikų, kurių gyvulininkystės ūkiai naudoja itin daug. Be to, procesas vyksta žymiai greičiau.
Skeptikus įmonė tildo ir prasidėjusiomis derybomis su JAV Agrokultūros departamentu (USDA). Šiuo metu svarstoma, kaip turėtų būtų reguliuojamas dirbtinis mėsos auginimas, kaip ją būtų galima įvesti į prekybos rinką. Mėsos tyrimų greičiausiai jau netrukus imsis JAV Maisto ir vaistų tarnyba.
Investuotojų susidomėjimas
Įmonių planais itin aktyviai domisi investuotojai. Didžiosios technologijų bendrovės jau yra išreiškusios norą dalyvauti dirbtinio mėsos auginimo procesuose.
„Memphis Meats“ jau pritraukė maždaug 2 mln. USD investicijų iš rizikos kapitalo fondų SOSV ir „New Crop Capital“.
„Microsoft“ įkūrėjas Billas Gatesas ir „Twitter“ kūrėjai Bizas Stone‘as bei Evanas Williamsas anksčiau investavo į kitas dvi mėsą laboratorijose auginančias įmones „Beyond Meat“ ir „Impossible Foods“.
Verslo susidomėjimas puikiai suprantamas, mat investicijų grąža gali būti milžiniška. Vien amerikiečiai per metus mėsai išleidžia 186 mlrd. USD.



















